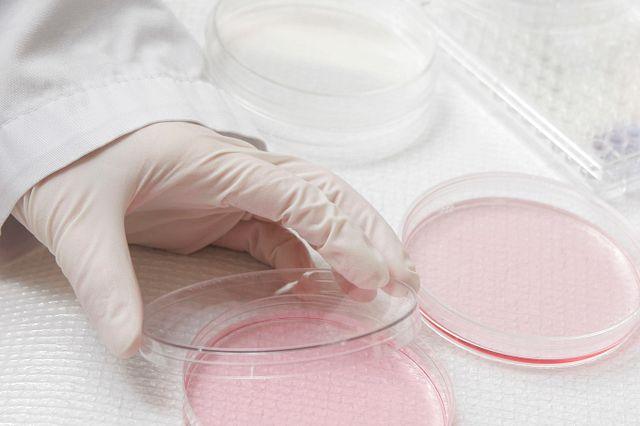
biocompatibility testing for medical devices laboratory analysis under ISO 10993

Biocompatibility testing for medical devices is a critical requirement for ensuring patient safety and achieving regulatory approval. Any device that comes into direct or indirect contact with the human body must prove that its materials do not cause toxicity, irritation, sensitization, or long-term biological harm.
At Materials Metric, we provide structured and science-driven biocompatibility assessment services aligned with global regulatory standards. Our goal is simple: help manufacturers achieve safe, compliant, and approval-ready medical devices.
What Is Biocompatibility Testing for Medical Devices?
Biocompatibility testing evaluates how medical device materials interact with biological systems. It determines whether a product is safe for its intended use.
The evaluation framework is defined by the International Organization for Standardization under the ISO 10993 series. In the United States, the U.S. Food and Drug Administration expects manufacturers to follow ISO 10993 principles when preparing regulatory submissions such as 510(k), PMA, and De Novo applications.
Biocompatibility testing for medical devices is not just a laboratory exercise. It is part of a risk management process that integrates material science, toxicology, chemistry, and regulatory strategy.
Need expert guidance on your biological evaluation plan?
Contact Materials Metric today to discuss your device classification and compliance pathway.
Why Biocompatibility Testing Is Essential
Medical devices interact directly with patients. Even small material inconsistencies can trigger:
Cytotoxic responses
Allergic reactions
Inflammation
Organ toxicity
Genetic mutations
Therefore, regulatory authorities require biological evaluation before market approval.
Biocompatibility testing for medical devices helps manufacturers:
Ensure patient safety
Avoid regulatory delays
Reduce liability risk
Support global submissions
Accelerate time to market
When performed strategically, it becomes a competitive advantage rather than just a compliance requirement.
Understanding the ISO 10993 Framework
The ISO 10993 series uses a risk-based approach. Not every device requires every test. Instead, testing depends on:
Type of body contact (skin, mucosal membrane, blood, implant)
Duration of exposure (limited, prolonged, permanent)
Material composition
Manufacturing processes
Key sections include:
ISO 10993-1 – Biological Evaluation Within Risk Management
Defines the strategy for selecting endpoints.
ISO 10993-5 – Cytotoxicity Testing
Evaluates potential cell damage.
ISO 10993-10 – Irritation and Sensitization
Assesses inflammatory and allergic responses.
ISO 10993-18 – Chemical Characterization
Identifies extractables and leachables from materials.
ISO 10993-17 – Toxicological Risk Assessment
Determines acceptable exposure limits.
At Materials Metric, we integrate all applicable ISO 10993 parts into a customized biological evaluation strategy tailored to your device.
Unsure which ISO 10993 tests your device requires?
Request a gap analysis from Materials Metric and receive a structured compliance roadmap.
Types of Biocompatibility Testing for Medical Devices
The selection of tests depends on device classification and exposure profile. Below are the most common evaluations.
Cytotoxicity Testing
This is typically the first screening test. It determines whether device extracts cause cell death or inhibit cell growth.
Sensitization Testing
Evaluates whether materials may trigger allergic reactions.
Irritation Testing
Assesses localized tissue inflammation after exposure.
Genotoxicity Testing
Determines whether materials could cause DNA damage or mutations.
Hemocompatibility Testing
Required for blood-contacting devices such as catheters or vascular implants.
Implantation Studies
Assesses tissue response to implanted materials over time.
Extractables and Leachables Testing
Identifies chemical substances that may migrate from device materials during use.
Toxicological Risk Assessment
A scientific justification comparing chemical exposure levels against safety thresholds.
Materials Metric emphasizes early chemical characterization. This approach can often reduce unnecessary animal testing and strengthen regulatory submissions.

FDA Expectations for Biocompatibility Testing
The FDA requires detailed documentation to support biological safety. Submissions must include:
Biological Evaluation Plan (BEP)
Biological Evaluation Report (BER)
Chemical characterization data
Toxicological risk assessment
Scientific justification for omitted tests
Incomplete documentation is one of the most common reasons for regulatory delays. Therefore, a structured approach is essential.
Materials Metric supports clients with complete regulatory-ready documentation aligned with FDA and global standards.
Preparing for a 510(k) or CE submission?
Partner with Materials Metric to ensure your biocompatibility testing meets FDA and ISO 10993 expectations.
Global Regulatory Considerations
While ISO 10993 is internationally recognized, regulatory interpretations can vary across regions. Manufacturers pursuing CE marking, UKCA, or other international approvals must ensure documentation aligns with regional expectations and notified body review standards.
Materials Metric supports global submission strategies by:
Aligning testing with multiple regulatory frameworks
Providing defensible scientific rationales
Coordinating with accredited laboratories
Supporting responses to regulatory queries
Common Biocompatibility Challenges
Manufacturers often face:
Material changes after design freeze
Sterilization-related extractables
Supplier documentation gaps
Legacy device remediation
Failed cytotoxicity or sensitization results
Regulatory deficiency letters
Our team conducts root cause analysis, develops remediation strategies, and redesigns biological evaluation pathways when necessary.
Why Partner with Materials Metric?
At Materials Metric, we go beyond test coordination. We act as your scientific and regulatory partner by:
Designing risk-based biological evaluation strategies
Performing chemical characterization reviews
Conducting toxicological risk assessments
Preparing BEP and BER documentation
Supporting FDA 510(k), PMA, and global submissions
Reducing time-to-approval through proactive planning
Our structured methodology ensures your device is not only tested — but strategically positioned for regulatory success.
Start Your Biocompatibility Compliance Journey
Biocompatibility testing for medical devices is complex, but with the right expertise, it becomes manageable and predictable.
Whether you are developing a new device, modifying materials, or responding to a regulatory deficiency, Materials Metric is ready to support you.
Preparing for a 510(k) or CE submission?
Partner with Materials Metric to ensure your biocompatibility testing meets ISO 10993 and FDA expectations — efficiently, scientifically, and confidently.
Frequently Asked Questions (FAQ) – Materials Metric Biocompatibility Testing
What is biocompatibility testing for medical devices?
Biocompatibility testing evaluates how medical device materials interact with biological systems. It ensures that devices are safe for patients and compliant with regulatory standards. At Materials Metric, we provide end-to-end biocompatibility assessment aligned with ISO 10993 and FDA guidance.
Why is ISO 10993 compliance important?
The ISO 10993 series defines the standard for biological evaluation of medical devices. Compliance is essential to:
Ensure patient safety
Support FDA 510(k), PMA, or CE submissions
Avoid regulatory delays
Reduce liability risks
Materials Metric helps manufacturers achieve full ISO 10993 compliance with structured testing and documentation.
What types of biocompatibility tests are required?
The required tests depend on device type, body contact, and exposure duration. Common tests include:
Cytotoxicity (ISO 10993-5)
Sensitization and irritation (ISO 10993-10)
Genotoxicity
Hemocompatibility
Extractables & leachables analysis
Implantation studies
Materials Metric customizes test selection based on your device and regulatory pathway.
What is a Biological Evaluation Plan (BEP) and Report (BER)?
The BEP outlines your device’s intended use, material composition, and planned biocompatibility tests. The BER compiles all results, chemical characterization data, and toxicological risk assessments. Materials Metric prepares regulator-ready BEP and BER to streamline FDA and global submissions.
Can biocompatibility testing reduce regulatory risk?
Yes. Proper testing ensures devices meet ISO 10993 standards and FDA expectations, preventing review deficiencies or delays. Early-stage chemical characterization and toxicological risk assessments from Materials Metric can minimize unnecessary testing and accelerate approval.
How does Materials Metric help with extractables and leachables testing?
Materials Metric performs comprehensive extractables and leachables (E&L) analysis to identify potential chemical migration from device materials. This data supports toxicological risk assessment and strengthens your regulatory submission.
Are all medical devices required to undergo biocompatibility testing?
Most devices that contact the human body — directly or indirectly — must be evaluated. Testing requirements vary by device type, duration of exposure, and risk classification. Materials Metric provides tailored guidance to determine which ISO 10993 tests are essential for your device.
How can biocompatibility testing improve patient safety?
By identifying cytotoxic, allergenic, or inflammatory risks before clinical use, biocompatibility testing protects patients from adverse reactions. Materials Metric integrates risk management with testing strategies to ensure maximum safety and regulatory compliance.
Can Materials Metric support global regulatory submissions?
Yes. We align our testing and documentation with FDA, CE, UKCA, and other international regulatory requirements. This ensures that your device is ready for multiple markets while minimizing review cycles.
How do I start biocompatibility testing with Materials Metric?
Simply contact Materials Metric to discuss your device classification, risk profile, and regulatory pathway. We provide:
Gap analysis for ISO 10993 testing
Customized Biological Evaluation Plan
Complete laboratory testing and toxicological assessment
Regulatory-ready BEP and BER
Ensure your medical device is safe, compliant, and approval-ready with Materials Metric’s expert biocompatibility testing services.
People Also Search For: Biocompatibility testing services for medical devices, ISO 10993 compliance checklist, FDA biocompatibility requirements for devices, Cytotoxicity testing laboratories, Sensitization and irritation testing ISO 10993, Extractables and leachables testing for medical devices, Toxicological risk assessment for medical devices, Biological evaluation plan (BEP) preparation, Biological evaluation report (BER) guidance, CE marking and FDA submission support, Implantable device biocompatibility testing, Risk-based biological evaluation ISO 10993, Materials Metric biocompatibility services, Medical device safety and regulatory compliance, ISO 10993-1 biological evaluation within risk management, ISO 10993-5 cytotoxicity testing standards, ISO 10993-10 irritation and sensitization tests, ISO 10993-17 toxicological risk assessment, ISO 10993-18 chemical characterization, Reducing regulatory delays in medical device approval, Biocompatibility testing for cardiovascular implants, Animal testing alternatives for medical devices, Regulatory-ready documentation for FDA and CE, Early chemical characterization in medical devices, Medical device material testing services, toxicological risk assessment, extractables and leachables testing, Materials Metric



